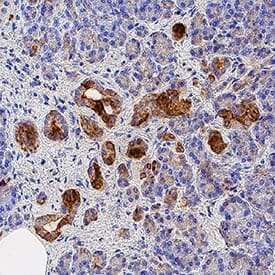

Human/Mouse/Rat Lipocalin-2/NGAL Antibody
R&D Systems, part of Bio-Techne | Catalog # AF1757


Key Product Details
Species Reactivity
Validated:
Cited:
Applications
Validated:
Cited:
Label
Antibody Source
Product Specifications
Immunogen
Gln21-Gly198
Accession # P80188
Specificity
Clonality
Host
Isotype
Scientific Data Images for Human/Mouse/Rat Lipocalin-2/NGAL Antibody
Detection of Human Lipocalin‑2/NGAL by Western Blot.
Western blot shows lysates of Capan-1 human pancreatic adenocarcinoma cell line and human pancreas tissue. PVDF membrane was probed with 0.2 µg/mL of Goat Anti-Human/Mouse/Rat Lipocalin-2/NGAL Antigen Affinity-purified Polyclonal Antibody (Catalog # AF1757) followed by HRP-conjugated Anti-Goat IgG Secondary Antibody (Catalog # HAF109). A specific band was detected for Lipocalin-2/NGAL at approximately 22 kDa (as indicated). This experiment was conducted under reducing conditions and using Immunoblot Buffer Group 1.Detection of Mouse and Rat Lipocalin-2/NGAL by Western Blot.
Western blot shows lysates of mouse and rat bone marrow. PVDF membrane was probed with 0.2 µg/mL of Goat Anti-Human/Mouse/Rat Lipocalin-2/NGAL Antigen Affinity-purified Polyclonal Antibody (Catalog # AF1757) followed by HRP-conjugated Anti-Goat IgG Secondary Antibody (Catalog # HAF017). A specific band was detected for Lipocalin-2/NGAL at approximately 22 kDa (as indicated). This experiment was conducted under reducing conditions and using Immunoblot Buffer Group 1.Detection of Human Lipocalin-2/NGAL by Simple WesternTM.
Simple Western lane view shows lysates of Capan-1 human pancreatic adenocarcinoma cell line, loaded at 0.2 mg/mL. A specific band was detected for Lipocalin-2/NGAL at approximately 34 kDa (as indicated) using 2 µg/mL of Goat Anti-Human/Mouse/Rat Lipocalin-2/NGAL Antigen Affinity-purified Polyclonal Antibody (Catalog # AF1757) followed by 1:50 dilution of HRP-conjugated Anti-Goat IgG Secondary Antibody (Catalog # HAF109). This experiment was conducted under reducing conditions and using the 12-230 kDa separation system.Applications for Human/Mouse/Rat Lipocalin-2/NGAL Antibody
Immunohistochemistry
Sample: Immersion fixed paraffin-embedded sections of human pancreas
Simple Western
Sample: Capan‑1 human pancreatic adenocarcinoma cell line
Western Blot
Sample: Capan‑1 human pancreatic adenocarcinoma cell line and human pancreas tissue
Reviewed Applications
Read 2 reviews rated 4 using AF1757 in the following applications:
Formulation, Preparation, and Storage
Purification
Reconstitution
Formulation
*Small pack size (-SP) is supplied either lyophilized or as a 0.2 µm filtered solution in PBS.
Shipping
Stability & Storage
- 12 months from date of receipt, -20 to -70 °C as supplied.
- 1 month, 2 to 8 °C under sterile conditions after reconstitution.
- 6 months, -20 to -70 °C under sterile conditions after reconstitution.
Background: Lipocalin-2/NGAL
Members of Lipocalin family share a highly conserved fold with an eight-stranded antiparallel beta barrel, and act as a transporters, carrying small molecules to specific cells. Lipocalin-2, also known as Neutrophil Gelatinase-Associated Lipocalin (NGAL), was originally identified as a component of neutrophil granules. It is a 25 kDa protein existing in monomeric and homo- and heterodimeric forms, the latter as a dimer with human neutrophil gelatinases (MMP-9). Its expression has been observed in most tissues normally exposed to microorganism, and its synthesis is induced in epithelial cells during inflammation. Lipocalin-2 has been implicated in a variety of processes including cell differentiation, tumorigenesis, and apoptosis. Studies indicate that Lipocalin-2 binds a bacterial catecholate sidropore bound to ferric ion such as enterobactin with a subnanomolar dissociation constant (Kd = 0.41 nM). The bound ferric enterobactin complex breaks down slowly in a month into dihydroxybenzoyl serine and dihydroxybenzoic acid (DHBA). It also binds to a ferric DHBA complex with much less Kd values (7.9 nM). Secretion of Lipocalin‑2 in immune cells increases by stimulation of Toll-like receptor as an acute phase response to infection. As a result, it acts as a potent bacteriostatic reagent by sequestering iron. Moreover, Lipocalin-2 can alter the invasive and metastatic behavior of Ras-transformed breast cancer cells in vitro and in vivo by reversing epithelial to mesenchymal transition inducing activity of Ras, through restoration of E-cadherin expression, via effects on the Ras-MAPK signaling pathway.
Long Name
Alternate Names
Gene Symbol
UniProt
Additional Lipocalin-2/NGAL Products
Product Documents for Human/Mouse/Rat Lipocalin-2/NGAL Antibody
Product Specific Notices for Human/Mouse/Rat Lipocalin-2/NGAL Antibody
For research use only